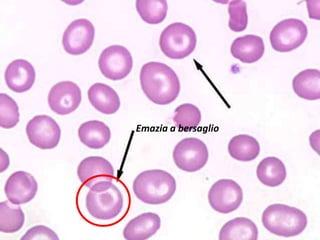
Emazia a bersaglio
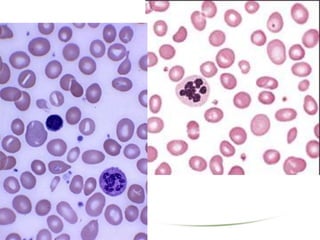

Il documento descrive diverse malattie tropicali non infettive, evidenziando la malattia reumatica, l'ipertensione arteriosa, le cardiomiopatie e le anemie comuni in Africa. Vengono analizzati i fattori di rischio, le diagnosi e le terapie per queste patologie, con particolare attenzione alla prevenzione e alla medicina scolastica. Infine, si discute l'impatto delle malattie ematologiche e si forniscono indicazioni per la gestione clinica.